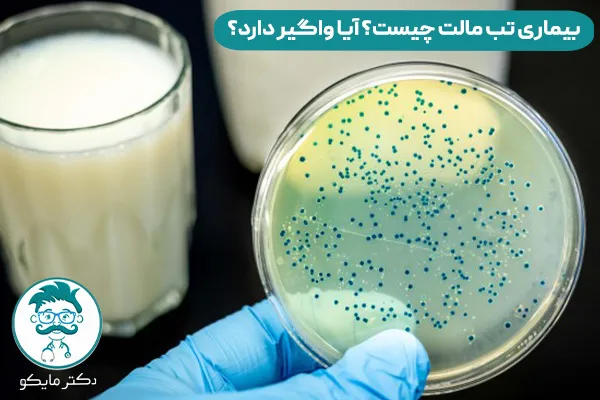
بیماری تب مالت چیست؟

بیماری تب مالت یا بروسلوز نوعی بیماری عفونی مشترک بین انسان و دام است که عامل آن باکتریای به نام بروسلا است. این باکتریها بیشتر در حیواناتی مانند گاو، بز، گوسفند و شتر یافت میشوند. بیماری تب مالت از دستهی بیماریهای قابل انتقال از حیوان به انسان بهشمار میرود و با توجه به علائم متغیر و غیراختصاصیاش، گاهی به آن لقب «بیماری هزار چهره» داده میشود.
عامل بیماری تب مالت چیست؟
بروسلاها گروهی از باکتریهای گرم منفی هستند که به صورت داخل سلولی در بدن میزبان زنده میمانند. چند نوع بروسلا وجود دارد که هر یک در نوع خاصی از حیوانات غالباند. برای نمونه:
| احتمال انتقال به انسان | میزبان اصلی | نوع بروسلا |
| بسیار بالا | بز و گوسفند | B. melitensis |
| بالا | گاو | B. abortus |
| متوسط | خوک | B. suis |
| پایین | سگ | B. canis |
از کجا بفهمم تب مالت دارم؟
بیماری تب مالت در بسیاری از کشورها از جمله ایران شیوع دارد، بهویژه در مناطق روستایی و عشایری که دامداری سنتی رواج دارد. این بیماری عفونی نهتنها باعث ناتوانی طولانیمدت در افراد مبتلا میشود، بلکه بار اقتصادی و اجتماعی زیادی نیز به دنبال دارد. همچنین، بروسلوز یکی از بیماریهایی است که در لیست بیماریهای قابل گزارش سازمان بهداشت جهانی قرار دارد.

علائم تب مالت در بزرگسالان
علائم بیماری تب مالت (بروسلوز) شامل تب، لرز، تعریق (به ویژه شبانه)، درد عضلانی، درد مفاصل (به ویژه در لگن، زانو و کمر)، خستگی، کاهش اشتها و کاهش وزن است. همچنین ممکن است علائمی مانند سردرد، کمردرد، درد شکم و علائم عصبی نیز دیده شود. در برخی موارد، تب مالت میتواند منجر به عوارضی مانند آبسه در اندامهای مختلف، درگیری قلب، استخوانها، مغز و کبد شود.
علائم بروسلوز یا تب مالت میتوانند مشابه آنفولانزا، مالاریا یا بیماریهای روماتیسمی باشند. فرد مبتلا ممکن است ماهها با علائمی مانند خستگی، تب خفیف یا درد مفاصل زندگی کند بدون آنکه بیماریاش تشخیص داده شود. این مسئله باعث میشود که تب مالت در موارد زیادی دیر تشخیص داده شود، به درمان پاسخ ندهد و مزمن شود. در برخی افراد، بیماری به اندامهایی مانند قلب، استخوانها یا سیستم عصبی مرکزی حمله میکند که نیاز به درمانهای پیچیده و طولانی دارد.

علائم تب مالت استخوانی
درگیری استخوانی ناشی از بیماری تب مالت یکی از عوارض مهم و دردناک این بیماری است که بیشتر در موارد مزمن یا درماننشده دیده میشود. در ادامه، شرح مختصری از علائم مرتبط با بروسلوز استخوانی آوردهام:
- درد استخوانها و مفاصل به ویژه در نواحی ستون فقرات، لگن، زانو و کمر، که میتواند با التهاب موضعی یا تورم همراه باشد.
- اسپوندیلیت بروسلایی (التهاب مهرهها) شایعترین نوع درگیری استخوانی است و اغلب مهرههای کمری و سینهای را درگیر میکند. بیمار ممکن است از خشکی صبحگاهی یا درد شدید هنگام حرکت شکایت کند.
- آرتریت (التهاب مفصل) در تب مالت میتواند بهصورت دردناک، متورم و گرم در یک یا چند مفصل ظاهر شود، به ویژه در مفاصل بزرگ.
- استئومیلیت (عفونت استخوانی) از دیگر عوارض کمتر شایع ولی شدید این بیماری است، که معمولاً نیاز به درمان طولانی و در مواردی جراحی دارد.
- کاهش توانایی حرکت و فعالیت روزمره، بهویژه در کودکان و سالمندان، که باعث محدودیت در زندگی روزانه میشود.
علائم تب مالت در زنان
علائم تب مالت زنان میتواند شامل طیف وسیعی از نشانهها باشد که با علائم بروسلوز در مردان مشترک است، اما برخی علائم ممکن است در زنان باردار یا در صورت درگیری اندامهای تناسلی زنان برجستهتر باشد. علائم کلی تب مالت شامل تب، تعریق شبانه، خستگی، درد مفاصل (به ویژه در لگن و کمر)، بی اشتهایی و کاهش وزن، درد شکم و سردرد است. علاوه بر این، تورم غدد لنفاوی و افسردگی نیز ممکن است از علائم این بیماری باشند.
آیا بیماری تب مالت واگیر دارد؟ راههای انتقال بروسلوز
بیماری تب مالت واگیردار است یا نه؟ بروسلوز معمولاً از طریق تماس مستقیم یا غیرمستقیم با حیوانات آلوده یا محصولات آنها به انسان منتقل میشود. در ادامه به مهمترین روشهای انتقال اشاره میکنیم:

- مصرف لبنیات غیرپاستوریزه: اصلیترین راه انتقال، نوشیدن شیر خام یا خوردن پنیر و کرهی تهیهشده از شیر آلوده است.
- تماس مستقیم با دام: به ویژه در دامداران، کارکنان کشتارگاهها و دامپزشکان؛ از طریق زخمهای باز یا مخاط.
- استنشاق آئروسلهای آلوده: که بیشتر در آزمایشگاهها یا محلهای فرآوری فرآوردههای حیوانی رخ میدهد.
- انتقال از مادر به جنین: در موارد نادر، از طریق جفت.
- تماس با خون، ترشحات یا بافتهای آلوده حیوانات: در فرآیند زایمان دام یا سقط جنین حیوان.
نکته مهم: بیماری تب مالت از فردی به فرد دیگر به راحتی منتقل نمیشود، اما مواردی از انتقال درونخانوادگی از طریق فرآوردههای آلوده گزارش شدهاند.
افراد در معرض تب مالت یا بروسلوز
مطالعات مختلف نشان دادهاند که برخی مناطق و گروههای خاص بیشتر در معرض ابتلا هستند. مناطق روستایی و عشایری به دلیل تماس مستقیم با دامها، کارکنان کشتارگاهها و آزمایشگاههای دامپزشکی که در معرض آئروسلهای آلوده هستند و مصرف کنندگان لبنیات سنتی بهویژه در مناطقی که فرهنگ استفاده از محصولات غیرپاستوریزه رواج دارد بیشتر در معرض ابتلا به تب مالت هستند.
بیماری تب مالت چه عوارضی دارد؟
عوارض تب مالت عبارتند از:

- عوارض عصبی: سردرد، درد مفاصل و عضلات، ضعف، بیخوابی، نگرانی، افسردگی، هذیان گفتن، مننژیت (التهاب پرده مغز)، تحریک پذیری زیاد و در موارد نادر، فلج.
- عوارض ارتوپدی: آرتریت (التهاب مفاصل) که میتواند مفاصل ران، مچ پا، دست، زانو و ستون فقرات را درگیر کند. این عارضه ممکن است باعث تورم، سفتی و درد مفاصل شود و در برخی موارد، آسیبهای دائمی به ستون فقرات و لگن وارد کند.
- عوارض قلبی عروقی: درگیری قلب و رگها که میتواند در موارد نادر به مرگ منجر شود.
- عوارض تولید مثلی: در مردان عفونت بیضهها و در زنان عفونت تخمدانها.
- عوارض روانی: افسردگی، اضطراب و سایر مشکلات روحی.
- عوارض دیگر: آبسه در استخوانها (به ویژه ستون فقرات) که میتواند منجر به زمینگیری شود، مشکلات شنوایی و عوارض گوارشی مثل دل درد.
تشخیص بیماری تب مالت
تشخیص تب مالت بهدلیل علائم غیراختصاصیاش، نیازمند دقت بالا و استفاده از روشهای آزمایشگاهی است. ابزارهای رایج تشخیصی عبارتاند از:
- آزمایشهای سرولوژیک: مانند تست رایت، 2-مرمن و کومبس که سطح آنتیبادی در خون را میسنجند.
- کشت باکتریایی: از نمونههای خونی یا مغز استخوان.
- PCR : تشخیص دقیق DNA باکتری در نمونهها.

راه درمان بیماری تب مالت چیست؟
سوال اینجاست که بیماری تب مالت درمان دارد یا نه؟ درمان بروسلوز معمولاً شامل مصرف حداقل دو نوع آنتیبیوتیک به صورت هم زمان برای جلوگیری از مقاومت دارویی و عود بیماری است. درمان بسته به مرحله بیماری، سن بیمار، عوارض و شرایط فیزیولوژیکی (مانند بارداری) ممکن است متغیر باشد.
دارو برای درمان تب مالت
در جدول زیر، رایجترین ترکیبهای دارویی برای درمان بیماری تب مالت آورده شدهاند:
| کاربرد | مدت زمان درمان | نحوه مصرف | ترکیب دارویی |
| بزرگسالان و موارد غیرپیچیده | 6 تا 8 هفته | خوراکی | داکسیسیکلین + ریفامپین |
| موارد شدید یا استخوانی | 6 هفته + 2 هفته تزریق | خوراکی و تزریقی | داکسیسیکلین + استرپتومایسین |
| حساسیت به استرپتومایسین | 6 هفته + 1 هفته تزریق | خوراکی و تزریقی | داکسیسیکلین + جنتامایسین |
| بارداری یا کودکان | 6 تا 12 هفته | خوراکی | کوتریموکسازول + ریفامپین |
علاوه بر درمان دارویی، برخی اقدامات حمایتی میتوانند روند بهبودی را تسهیل کنند:
- استراحت کافی به ویژه در هفتههای اول درمان برای کاهش خستگی و دردهای عضلانی.
- تغذیه مقوی و سبک شامل میوه، سبزیجات، منابع پروتئینی و مایعات کافی جهت حفظ توان بدنی.
- کنترل علائم ثانویه مانند تب با استفاده از استامینوفن یا داروهای ضدالتهاب در صورت نیاز.
- پایش عملکرد ارگانها مثل کلیه، کبد، مغز استخوان و ستون فقرات در صورت وجود عوارض خاص.
درمان بیماری تب مالت مزمن چگونه است؟
در برخی موارد، تب مالت به مرحلهی مزمن وارد میشود یا ارگانهای خاصی مانند استخوان، قلب یا سیستم عصبی را درگیر میکند. در این حالت:

- درمان طولانیتر (تا 3 ماه) مورد نیاز است.
- استفاده از آنتیبیوتیکهای تزریقی یا جایگزینها مثل فلوروکینولونها یا ترکیبات سهدارویی توصیه میشود.
- درگیری استخوانی یا اسپوندیلیت نیاز به پایش ارتوپدی، تصویربرداریهای دورهای و گاهی جراحی دارد.
- درگیری مغزی یا اندوکاردیت باید در بیمارستان تحت درمان چندتخصصی قرار گیرد.
درمان تب مالت در گروههای خاص
- زنان باردار: استفاده از داروهای بیخطر مانند کوتریموکسازول و ریفامپین، پرهیز از داکسیسیکلین یا استرپتومایسین.
- کودکان: مصرف داروهایی با دوز مناسب، پرهیز از داکسیسیکلین زیر ۸ سال بهدلیل عوارض رشد دندانی.
- افراد مسن یا بیماران زمینهای: نظارت بیشتر بر عوارض دارویی، عملکرد کلیه و قلب.
چه چیزی برای درمان بیماری تب مالت خوب است؟
درمان بیماری تب مالت نیازمند رعایت دقیق برنامه دارویی و انجام مراقبتهای حمایتی است. در ادامه، به مهمترین مواردی که در روند درمان مؤثر هستند، بهصورت خلاصه اشاره میکنم:

- مصرف کامل داروهای آنتیبیوتیک طبق تجویز پزشک، بهویژه داروهایی مانند داکسیسیکلین، ریفامپین یا استرپتومایسین که باید حداقل ۶ تا ۸ هفته مصرف شوند.
- استراحت کافی و کاهش فعالیت شدید بدنی برای کاهش درد عضلانی و خستگی، بهویژه در مراحل اولیه درمان.
- تغذیه مقوی و سبک شامل مصرف پروتئین کافی، میوه و سبزیجات تازه برای تقویت سیستم ایمنی بدن و جبران کاهش وزن.
- پایش علائم و پیگیری بالینی منظم به خصوص برای جلوگیری از عوارض مزمن و بررسی تأثیر داروها.
درمان سريع تب مالت؛ از آنتیبیوتیک تا مراقبتهای حمایتی
درمان بیماری تب مالت بر اساس استفاده همزمان از چند نوع آنتیبیوتیک با دوره مصرف طولانی است. رایجترین رژیمهای درمانی عبارتاند از:
| مدت درمان | دوز پیشنهادی | داروی اصلی |
| حداقل 6 هفته | 100 میلیگرم، دو بار در روز | داکسیسیکلین |
| حداقل 6 هفته | 600-900 میلیگرم در روز | ریفامپین |
| 2 تا 3 هفته | تزریقی، روزانه | استرپتومایسین (در موارد خاص) |
همچنین توصیه میشود بیماران پس از درمان، از نظر علائم مزمن مانند درد مفاصل یا خستگی شدید مورد پایش قرار گیرند.
درمان تب مالت چقدر طول میکشد؟
درمان تب مالت معمولاً بین 6 تا 8 هفته طول میکشد. ممکن است بسته به شدت بیماری و شرایط فردی، دوره درمان طولانیتر شود و حتی نیاز به درمانهای دیگری مانند تخلیه مناطق آلوده باشد. خطر عود بیماری پس از درمان کامل بین 5 تا 15 درصد است و معمولاً در 6 ماه اول پس از درمان رخ میدهد.

برنامههای ملی و جهانی کنترل بیماری تب مالت
مقابله با بیماری تب مالت نیازمند همکاری مؤثر بین نهادهای بهداشتی، دامپزشکی و جوامع محلی است. برنامههای کنترلی هم در سطح ملی و هم در سطح بینالمللی طراحی شدهاند تا از شیوع بیشتر بیماری جلوگیری شود.
برنامههای ملی در ایران
در ایران، وزارت بهداشت و سازمان دامپزشکی کشور تلاشهایی برای کنترل تب مالت انجام دادهاند که شامل موارد زیر است:
- واکسیناسیون گسترده دامها: استفاده از واکسن Rev-1 برای بز و گوسفند، در مناطق پرخطر.
- آزمایش غربالگری در دامها: شناسایی دامهای آلوده و حذف آنها از چرخه تولید.
- آموزش جوامع روستایی و عشایری: با هدف افزایش آگاهی در زمینه انتقال بیماری و روشهای پیشگیری.
- افزایش نظارت بهداشتی بر لبنیات سنتی: صدور مجوز تولید تنها برای واحدهای بهداشتی و کنترل کیفیت مستمر.
- برنامههای مشترک بین وزارت بهداشت و سازمان دامپزشکی: ایجاد سامانههای گزارشدهی آنلاین و نظارت متقابل.
اقدامات جهانی سازمان بهداشت جهانی (WHO) و OIE
سازمانهای بینالمللی نیز توجه ویژهای به تب مالت دارند. برخی برنامهها عبارتاند از:
- برنامه “One Health“: تأکید بر تعامل بین سلامت انسان، حیوان و محیط زیست.
- ارزیابی سالانه وضعیت بروسلوز در کشورها: پایش مداوم و تهیه نقشههای پراکندگی بیماری.
- برگزاری کارگاههای تخصصی منطقهای: برای انتقال تجربیات موفق کشورها به یکدیگر.
- ایجاد چارچوبهای حقوقی: برای کنترل تجارت دام و فرآوردههای دام در مناطق آلوده.
- تأمین منابع مالی و فنی برای کشورهای کمدرآمد: جهت اجرای برنامههای دامپزشکی و بهداشتی.
پیشگیری از بیماری تب مالت یا بروسلوز
پیشگیری، مؤثرترین راه در مقابله با بروسلوز است. راهکارهای زیر میتوانند نقش مهمی در کاهش شیوع بیماری ایفا کنند:

- پاستوریزه کردن لبنیات: مصرف شیر، پنیر و کره پاستوریزه از جمله اقدامات حیاتی در کاهش انتقال بیماری است.
- واکسیناسیون دامها: اجرای برنامههای واکسیناسیون گسترده برای دامها، بهویژه در مناطق پرخطر، بسیار مؤثر بوده است.
- آموزش جامعه و دامداران: آگاهیرسانی درباره روشهای پیشگیری، علائم بیماری و خطرات آن یکی از ابزارهای قدرتمند در کاهش میزان ابتلا است.
- ارتقای بهداشت کشتارگاهها و مراکز فرآوری: استفاده از تجهیزات حفاظتی و ضدعفونی مناسب در محیطهایی که تماس با دام و فرآوردههای آن وجود دارد.
- نظارت دولتی بر تولید و توزیع لبنیات سنتی: کنترل کیفیت محصولات لبنی سنتی میتواند نقش بزرگی در کاهش موارد ابتلا داشته باشد.
سخن پایانی
بیماری تب مالت یکی از مهمترین بیماریهای مشترک بین انسان و دام است که شناخت، پیشگیری و کنترل آن نیازمند اقدامات چندجانبه است. در این مقاله تلاش کردیم با بررسی علمی و کاربردی ابعاد مختلف بیماری، دیدی جامع و روشن به مخاطب ارائه کنیم.
«اگر شما هم در مورد تب مالت اطلاعات یا سوالی دارید در قسمت نظرات با من و خوانندگان این مقاله به اشتراک بگذارید.»






1 دیدگاه
سلام من چندین سال مفصل هام درد میکنه احتمال رماتیسم دادن ولی جواب آزمایش هام منفی بود پزشک روماتولوژ گفت آرتروز هستش ممکنه تب مالت باشه؟